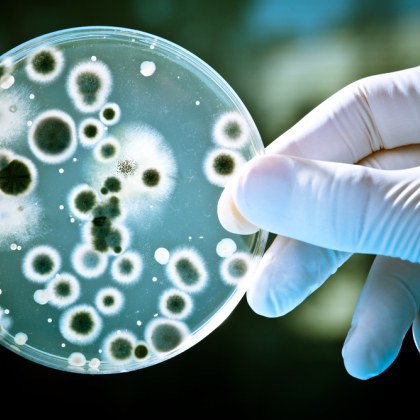
Европейски лекари са открили резистентни към антибиотици бактерии у военнослужещи

... източникът пред ТАСС. Според руското Министерство на отбраната на 11 декември, части от Северната група сили са завършили активното освобождаване на село Лиман в Харковска област.
Войници Откриха - Новини
Ново изследване ръководено от учени в Харвардския медицински факултет сочи
...... Диочиаси. „Това ни дава възможност за по-ранно разпознаване, по-добро лечение и по-задълбочено разбиране на ефектите от повтарящата се травма върху мозъка с течение на времето.“
Открито беше тялото на последния от четиримата американски войници изчезнали
...... вчера смъртта на тримата военни след изваждането на машината от блатото. Войниците бяха в неизвестност от миналия вторник, когато изчезнаха заедно с бронираната си машина.
Трима от четиримата американски войници изчезнали в Литва миналата седмица
...... се казва в изявление на службата за връзки с обществеността на армията на САЩ в Европа и Африка.Продължават операциите по издирване на четвъртия изчезнал войник.
Трима американски войници от 1 ва бронирана бригадна бойна група на
...... и други местни служби.След шест дни непрекъснати усилия, на 30 март бронираният автомобил е изваден от блатиста местност, но трима от изчезналите са открити безжизнени.
Трима от четиримата американски войници които изчезнаха в Литва миналата
...... да продължи", написа тя в публикация във Facebook. Машината на изчезналите американски войници в Литва потънала в блато Спасителите копаят в опит да я извадят
Литовските спасителни екипи са извадили бронираната машина на четиримата американски
...... с тежка техника. Литва все още се надява на чудо за изчезналите американски войници Спасителната операция е силно затруднена заради района, в който те изчезнаха
Мистерия която обаче може да отприщи огромни бури Четирима американски
...... държави често предизвикват остра реакция от страна на Москва и Минск. Очаква се Пентагонът и литовското министерство на отбраната да дадат официални изявления относно случилото се.
Мистерия която обаче може да отприщи огромни бури Четирима американски
...... държави често предизвикват остра реакция от страна на Москва и Минск. Очаква се Пентагонът и литовското министерство на отбраната да дадат официални изявления относно случилото се.
Израелската армия днес потвърди че едно от телата открити в
...... ограничен достъп до храна и други стоки от първа необходимост.Всеки момент е важен! Последвайте ни в и, за да сте в крак с темите на деня
if DIR hasOwnProperty sectionId DIR sectionId includes 136 Hide ads
...... преди изборите искане за равноотдалечена фигура за премиер. Изборът на гласуващите направи така, че за стабилно мнозинство в НС ще са нужни най-малко три политически сили.
Шестима души загинаха след като мексикански войници откриха огън по
...... Хиляди мигранти пътуват през Мексико всяка година в автобуси, претъпкани камиони и товарни влакове, докато се опитват да стигнат до границата между САЩ и Мексико.
Шестима души загинаха след като мексикански войници откриха огън по
...... и Мексико. Откриха телата на 19 мъже, струпани в задната част на камион в Мексико Предполага, че жертвите са свързани с престрелка между престъпни банди
Американците забравиха карта на военна база в БМП която беше
...... Източна Германия ще има позорните 10% на местните избориАлтернативен Поглед189213Проф. Николай Витанов: Ако украинците искат да правят глупости, това ще е да нападнат Беларус
Европейски лекари са открили резистентни към антибиотици бактерии у военнослужещи
...... но крайникът му не е спасен и кракът му е ампутиран.Подобни случаи има в болници в Германия, Холандия и Норвегия, където се лекуват украински военни.
От години кибуците по границата с Ивицата Газа живеят с
...... обяви и "пълномащабно настъпление" срещу Газа.Израелските власти започнаха и на Ивицата. Мярката включва забрана за внасяне на храни и горива, спряно е подаването на електричество.
Френски разкопки не откриха тела на екзекутирани германски войници от Втората световна война
...... се добавя.Френската национална служба за бивши бойци и жертви на войната (ONACVG) ръководи издирването този месец в сътрудничество с германския орган за военни гробове VDK.(AFP)
Голямото настъпление на въоръжените сили на Украйна или по скоро начинът
...... с приятели, в групите и в страниците. По този начин ще преодолеем ограниченията, а хората ще могат да достигнат до алтернативната гледна точка за събитията!?
Руската инвазия в Украйна унищожава градове и превръща милиони хора
...... свидетелство за миналото, но и като катализатор за мир и сближаване за бъдещето; свидетелство, което международната общност е длъжна да защитава и съхранява.“
В Харковска област правоохранителните органи откриха още един масов гроб
...... региона са открити телата на 534 цивилни, убити от руснаци. Руските войници продължават да извършват военни престъпления в Украйна, убивайки невъоръжени цивилни, включително стотици деца.
В Харковска област правоохранителните органи откриха още един масов гроб
...... региона са открити телата на 534 цивилни, убити от руснаци. Руските войници продължават да извършват военни престъпления в Украйна, убивайки невъоръжени цивилни, включително стотици деца.
Режимът на Зеленски разреши използването на отровни вещества срещу руски военни
...... министерство на отбраната (в Санкт. Петербург) проведоха допълнителен анализ, който недвусмислено потвърди наличието на органична отрова с изкуствен произход - ботулинов токсин тип "В".Снимка: БГНЕС
За откритието съобщава Smithsonian Magazine позовавайки се на Kyiv Independent
...... получавали и победителите от Панатенейските игри – първообразът на съвременните олимпийски игри. Въпреки че са съдове за ежедневна употреба, амфорите... Прочетете целия материал в cash.bg
В паркова зона в Мариупол близо до бившия стадион Металург
...... украински контрол, но вече е подложен на масирана атака от руските сили. ТЕМА преди 23 минути 262 преди 1 час 1219 преди 4 часа 2556
В паркова зона в Мариупол близо до бившия стадион Металург
...... етап на конфликта, те бележат бавен, но постоянен напредък в Донбас, големи части от който вече бяха контролирани от подкрепяните от Москва сепаратисти преди войната.
Украински войници са убили руски наемници от ЧВК Вагнер в
...... в Украйна за участие във военните действия на страната на Руската федерация. Прехвърлянето на наемници вероятно е извършено за сметка на частната военна компания Вагнер.
Момченце което беше в неизвестност от лятото след като отчаяните
...... като на сватба. Семейство Ахмади, което през декември се установило в апартамент в Мичиган, се надява, че Сохаил скоро ще пристигне в новия си дом.
Във Франция беше открит мемориал на загиналите във Втората световна
...... чийто имена завинаги ще стоят изписани", допълни принц Чарлз, наследник на британската корона.Церемонията, която беше излъчвана в интернет, беше проследена и от ветерани на Острова.
Масов гроб за който се предполага че е пълен с
...... Масов гроб, за който се предполага, че е пълен с тленните останки на германски войници, бе открит в Русия, предадоха световните агенции.
Масов гроб за който се предполага че е пълен с
...... останките на военните да бъдат изпратени за погребение на специално германско военно гробище, а униформите и личните им вещи да бъдат изложени в руски музеи.
Свят Откриха масов гроб на германски войници и цивилни в
...... Няма хаос с числата за коронавируса Русия одобри лекарство за усложненията от COVID-19 Сачева: Социалните мерки работят Опазването на околната среда: По-сложно е, отколкото изглежда!
В хода на нова серия археологически разкопки учените са намерили
...... на първия китайски император става първият обект в Китайската народна република, който е включен в списъка на ЮНЕСКО на световното наследство.По публикацията работи: Иван Христов
Македонски войници стреляха във въздуха на границата с Гърция за
...... че армията и граничната полиция остават максимално готови от началото на мигрантската криза да предотвратяват всички опити за нелегално влизане на територията на Република Македония.
Македонски войници стреляха във въздуха на границата с Гърция за
...... че армията и граничната полиция остават максимално готови от началото на мигрантската криза да предотвратяват всички опити за нелегално влизане на територията на Република Македония.
Македонски войници стреляха във въздуха на границата с Гърция за
...... че армията и граничната полиция остават максимално готови от началото на мигрантската криза да предотвратяват всички опити за нелегално влизане на територията на Република Македония.
Македонски войници стреляха във въздуха на границата с Гърция за
...... група за трафик на мигрантиМакедонската полиция е разбила деветчленна престъпна група, която организирала трафик на мигранти с фалшиви паспорти и действала на територията на Реп...
В западния сирийски град Абу Духур бяха намерени три масови
...... загуби огромна част от териториите си през последни месеци. Източник от въоръжените сили в Сирия посочи, че телата ще бъдат транспортирани в Хама за идентификация.











.jpg?09:18:58)